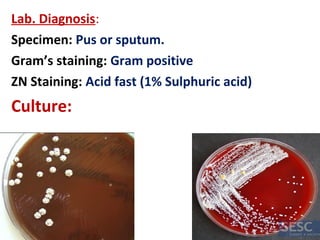
Lab. Diagnosis:
Specimen: Pus or sputum.
Gram’s staining: Gram positive
ZN Staining: Acid fast (1% Sulphuric acid)
Culture:

The document discusses the normal microbial flora found on and within the human body of healthy individuals. It describes the various factors that influence the composition of the normal flora and defines resident and transient flora. It then provides details on the normal flora found at different anatomical sites of the body including skin, eyes, nose, mouth, ears, genitourinary and gastrointestinal tracts. It lists examples of common bacterial species found at each site and discusses their roles and benefits in maintaining human health.